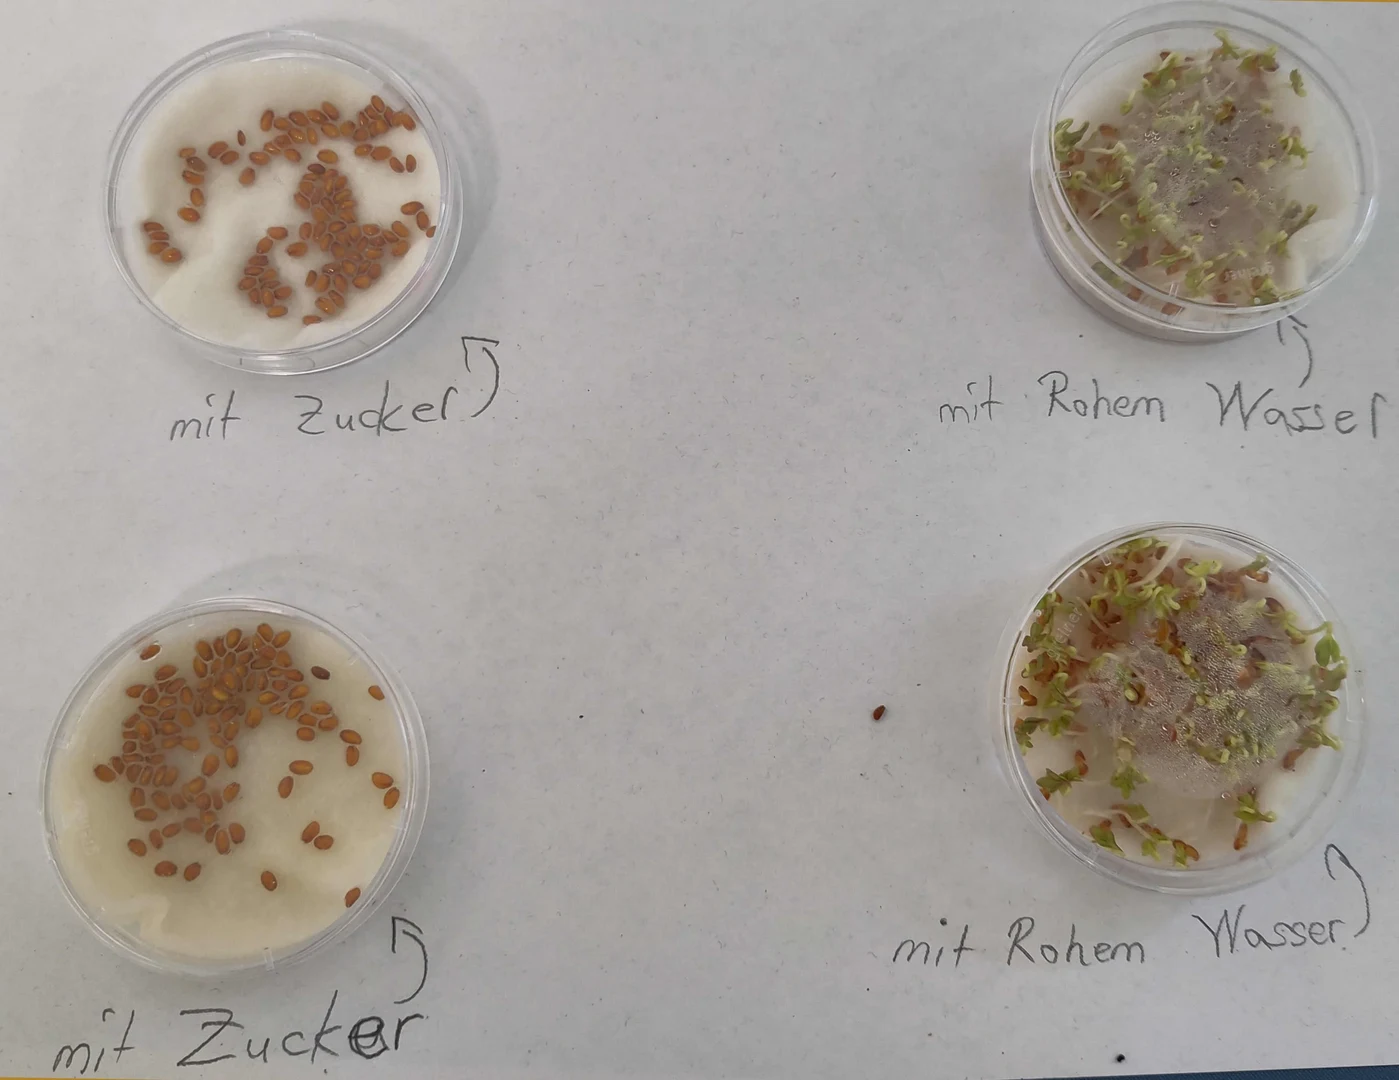
Keimungsexperimente

In der ersten Herbstferienwoche, vom 13. bis 17. Oktober 2025, nahmen 15 Mädchen und Jungen im Alter von 7 bis 12 Jahren mit Begeisterung am Programm zu Samen, Früchten und Ausbreitungsbiologie teil. Die Kinder lernten, wie Samen und Früchte aus Blüten entstehen, wie Samen aufgebaut sind und wie sie keimen.
Zur Keimung wurden Experimente mit verschiedenen Keimungsbedingungen durchgeführt. Nachdem die Kinder eine große Auswahl an Samen und Früchte den verschiedenen Ausbreitungsmöglichkeiten zugeordnet hatten, machten insbesondere die Flugversuche mit Flugfrüchten und nachgebauten Fliegern besonders Spaß. Im Nutzpflanzengarten erfuhren die Kinder viel Wissenswertes über die Züchtung verschiedener Obst- und Gemüsesorten. Bei einer Blindverkostung nahmen die Kinder die Obstvielfalt mit allen Sinnen wahr.
Auch in die Arbeit unserer Gärtnerinnen und Gärtner bekamen die Kinder einen Einblick: Die Samen aus verschiedenen Fruchtständen wurden professionell gereinigt und jedes Kind konnte ein Tütchen einer Pflanze seiner Wahl, die es selbst gereinigt hatte, mit nach Hause nehmen. An den letzten beiden Tagen ging es auch viel um die Vielfalt an Pflanzen, die Bestandteil unserer Ernährung sind und wie man sich nachhaltig regional, saisonal und rational ernähren kann.
Alle Infos zum Ferienprogramm der Grünen Schule finden Sie hier auf unserer Homepage.